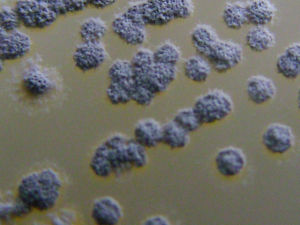
微生物資源 微生物資源

主要分類
農業微生物
中國高校工業微生物資源工業微生物
2000年保藏各類工業微生物菌種1842株,基本上包涵了食品與發酵行業各類生產及科研用微生物。向國內外生產企業和研究機構提供1002份生產和實驗用菌。2001年出版了《中國工業微生物菌種目錄》第二版。1981-1984年實施“工業微生物菌種分類鑑定命名編目的研究”計畫,對1296株收集菌種分期分批進行了鑑定、命名和編目,建立了中國工業微生物菌種資源和檔案庫,結束了來源不清、分類混亂、分散保藏、重複管理的局面。1984-1986年,承擔《酒類、醬油黴菌和酵母菌生產性能測定的研究》,測定868株菌種,基本上摸清了重要生產性能的主要參數,並從中篩選出近百株有特性和具有一定適用價值的菌種。
醫學微生物
微生物資源1983-1985年醫學菌種中心與WHO協作組織了肺炎鏈球菌收集、鑑定和分型研究,有11個省、直轄市共29個醫院參加了協作。3年中從病人的腦脊液、血液、胸水和中耳液分離了1000多株菌種。經系統鑑定確定712株為肺炎鏈球菌,分出了40個血清型,其中兩個血清型為中國特有。這套血清型菌種是我國最全的一套分型用菌種,已用於肺炎球菌多糖疫苗生產用菌種。
1975-1980年腦膜炎專業實驗室在全國15個省、直轄市進行奈瑟氏菌種的收集和鑑定。5年共收集2500株,分出了12個血清型,其中H、I、K三個血清型屬中國最早發現,已被國際認可和使用。
自20世紀60年代中期,開展鉤端螺鏇體的收集,共收集了3000多株,分出了67個血清型,其中有1個血清型屬中國特有。有7個血清型的菌種作為鉤端螺鏇體疫苗生產用菌種。鉤端螺鏇體專業實驗室於1986年被WHO確定為國際專業實驗室。
另外,在沙門氏菌屬、摩拉氏菌屬等也進行了全國性收集和調查,收集到一些非常有價值的菌種,廣泛用於預防、治療和診斷用菌種。
獸醫微生物設在中國獸醫藥品監察所的中國獸醫微生物菌種保藏管理中心,同時在中國農業科學院哈爾濱獸醫研究所、蘭州獸醫研究所和上海家畜寄生蟲病研究所設立了菌種保藏分中心,承擔全國獸醫生物製品生產檢驗及科研、教學實驗用菌的供應任務。現保藏菌種50屬230種3741株。主要是冷凍乾燥保藏。這些菌種生產的獸藥生物制口在我國豬瘟、馬傳貧、新城疫、牛疫、仔豬副傷寒等重大病防治中發揮了決定性作用,創造了巨大的經濟和社會效益。其中的豬瘟兔化弱毒、馬傳貧弱毒、布氏桿菌豬2號弱毒和仔豬副傷寒弱毒株獲得國家高度重視。豬瘟弱毒株和牛瘟弱毒株在控制豬瘟和消滅牛瘟中起決定性作用。1992年出版《中國獸醫菌種目錄》(中英文合訂本)第一版。
林業微生物2000年保藏林業微生物菌科200屬400種730株。包括林業用蘇雲金桿菌、林木病原菌、林木昆蟲病毒、大型真菌和木腐菌等。對外供應菌種78株。
保藏的林木菌根真菌及蘇雲金桿菌產業化產品和蘇雲金桿菌的殺蟲蛋白基因已套用於林木遺傳育種。
藥用微生物設在中國醫學科學院生物技術研究研究所的中國抗菌素菌種保藏管理中心(分支機構有四川抗菌素工業研究所及華北製藥廠抗菌素研究所的菌種保藏分中心)。2000年保藏菌種36屬290個種3000株。還為中國抗菌素研究和生產提供菌種。庫藏菌種中有許多菌株有重要的經濟價值,例如:康樂黴素、博安黴素、博寧黴素、戒台黴素、力達黴素、雲南黴素和山東黴素等產生菌。
維護保養
微生物菌種資源收集保藏管理
微生物與生物環境間的關係原國家科委於1979年批准成立中國微生物菌種保藏管理委員會,下設7個國家級專業菌種保藏管理中心(表2),分別負責農業、工業、林業、醫學、獸醫、藥用及普通微生物菌種資源的收集、鑑定、保藏、供應及國際交流任務。制訂了國家微生物菌種保藏管理條例。中國微生物菌種保藏管理委員會及下屬7個專業菌種中心,在國際菌種保藏聯合會(WFCC)註冊,並於1991年在北京主持召開“國際菌種保藏聯合會”第七屆大會。它是中國微生物菌種資源收集保藏工作的鼎盛時期。自20世紀90年代中期開始,一些菌種中心由於缺少經費而面臨解體,菌種保藏管理專業科技人員流失,菌種保藏庫及實驗室無力維修,國家菌種資源收集工作幾乎停頓,庫藏菌種的安全受到嚴重威協。直至1999年設立科技基礎性工作專項後,一些菌種保藏中心才逐步開展有計畫的收集、保藏工作。一些部門或地方,甚至學校和科研單位也建立了菌種保藏機構(表3)。2000年,7個國家級菌株保藏中心總計庫藏30613株。
國家級菌種保藏管理中心承擔國家微生物資源科技基礎性工作任務,是社會公益性事業單位。在不斷地為國家收集並長期有效保藏國家微生物菌種資源的同時,還持續不斷地為社會提供遺傳性穩定的菌種及信息。
表2中國國家級菌種保藏管理中心
| 名稱及成立年份 | 掛 靠 單 位 |
| 中國農業微生物菌種保藏管理中心(ACCC)—1980 | 中國農業科學院土壤肥料研究所 |
| 中國工業微生物菌種保藏管理中心(CICC)—1979 | 中國食品發酵工業研究院 |
| 中國醫學微生物菌種保藏管理中心(CMCC)—1979 | 中國藥品生物製品檢定所 |
| 中國獸醫微生物菌種保藏管理中心(CVCC)—1979 | 中國獸醫藥品檢定所 |
| 中國林業微生物菌種保藏管理中心(CFCC)—1985 | 中國林業科學研究院 |
| 中國抗菌素菌種保藏管理中心(CACC)—1979 | 中國醫學科學院醫藥生物技術研究所 |
| 中國普通微生物菌種保藏管理中心(CCGMC)—1979 | 中國科學院微生物研究所 |
| 名 稱 | 所 在 單 位 |
| 中國典型培養物保藏中心(CCTCC) | 武漢大學 |
| 上海農業基因中心 | 上海市農業科學院 |
| 華中農業大學菌種保藏中心(CCDM) | 華中農業大學 |
| 北京農業大學菌種中心 | 中國農業大學 |
| 海洋微生物中心(CMBGCAS) | |
| 香港大學保藏中心(HKUCC) | 香港大學 |
| 香港中文大學保藏中心(CUHK) | 香港中文大學 |
| 台灣生物資源保藏研究中心(BCRC) | 台灣新竹 |
微生物資源保存狀況
微生物資源中國普通微生物菌種保藏管理中心的分支機構-病毒保藏管理中心設在中國科學院武漢病毒研究所。
工作進展
國家設立了“科技基礎性工作專項資金項目”,中國科學院實施了生物及標本基礎性工作建設項目,農業微生物菌種中心、抗菌素菌種中心及普通微生物中心都得到了專項資金的支持,使我國菌種保藏工作有較大進展。2001年各菌種保藏中心共庫藏菌種32987株,對外供應菌種17199份(表4)。
表4國家菌種保藏管理中心2001年庫藏菌種及供應菌種統計
| 名 稱 | 庫 藏 菌 種 | 供應菌種(份) | ||
| 屬 | 種 | 菌株 | ||
| 中國普通微生物菌種保藏管理中心 | 529 | 2670 | 14806 | 5500 |
| 中國農業微生物菌種保藏管理中心 | 166 | 510 | 3365 | 2000 |
| 中國林業微生物菌種保藏管理中心 | 1100 | 49 | ||
| 中國醫學微生物菌種保藏管理中心 | 38 | 250 | 4000 | 5600 |
| 中國獸醫微生物菌種保藏管理中心 | 230種(群) | 3800 | 1792 | |
| 中國工業微生物菌種保藏管理中心 | 67 | 251 | 1863 | 1258 |
| 中國抗菌素菌種保藏管理中心 | 4053 | 1000 | ||
| 合 計 | 32987 | 17199 |
資源平台
國家微生物資源平台於2011年11月由科技部、財政部認定通過,其依託部門為農業部,依託單位為中國農業科學院農業資源與農業區劃研究所,是首批認定的23個國家科技基礎條件平台之一。
國家微生物資源平台是保證國家微生物資源庫藏安全的重要載體,工作宗旨是根據社會科技或行業發展的要求,收集、保藏各類微生物資源,持續擴充平台共享實物資源量,對資源信息進行規範性整理、整合,通過數據化和網路化手段進行及時有效的共享,促進帶動資源的共享利用,積極貫徹科技部、財政部“整合、共享、完善、提高”的方針,突出“以用為主、開放共享”,切實提高服務質量和數量,不斷提升開放能力和創新支撐能力,積極服務於社會發展和科技進步。
國家微生物資源平台涉及部門包括農業部、教育部、衛生部、中國科學院、國家林業局、國家海洋局、中國食品藥品監督管理局、中國輕工集團等部門,參建單位涉及中國農業科學院農業資源與農業區劃研究所、中國食品藥品檢定研究院、中國醫學科學院醫藥生物技術研究所、中國食品發酵工業研究院、中國獸醫藥品監察所、中國科學院微生物研究所、中國林業科學研究院森林生態環境與保護研究所、武漢大學、國家海洋局第三海洋研究所等單位。國家微生物資源平台運行服務的核心機構為中國農業微生物菌種保藏管理中心、中國醫學細菌保藏管理中心、中國藥學微生物菌種保藏管理中心、中國工業微生物菌種保藏管理中心、中國獸醫微生物菌種保藏管理中心、中國普通微生物菌種保藏管理中心、中國林業微生物菌種保藏管理中心、中國海洋微生物菌種保藏管理中心、中國典型培養物保藏管理中心。
根據《國家中長期科學和技術發展規劃》和《國家科技基礎條件平台建設綱要(2004-2010)》,國家於2003年啟動了自然科技資源平台建設項目。微生物資源作為自然科技資源的重要組成部分,也從當年開始進入自然科技資源平台建設,2003年度建設項目分別是中國農業科學院農業資源與農業區劃所主持的“微生物菌種資源描述規範研究制定及共享試點”(2003DEA3N028)和中國科學院微生物研究所主持的“創建微生物菌種資源共享體系”;2004年度為9個建設項目,分別由中國農業科學院農業資源與農業區劃研究所、中國食品藥品檢定研究院、中國醫學科學院醫藥生物技術研究所、中國食品發酵工業研究院、中國獸醫藥品監察所、中國科學院微生物研究所、中國林業科學研究院森林生態環境與保護研究所、武漢大學、國家海洋局第三海洋研究所等9個單位承擔;2005-2007平台建設項目為“微生物菌種資源”(2005DKA20200)。國家微生物資源平台建設工作分別以中國農業、醫學、藥用、工業、獸醫、普通、林業、典型培養物、海洋9個國家專業微生物菌種管理保藏中心為核心單位,覆蓋全國24個省市,在不同領域內組織資源優勢單位103家進行資源的標準開展微生物資源的整理整合,累計完成標準化整理16.2萬株,多媒體信息4.5萬幅,截止到2008年底,完成整合入庫的菌種資源約占國內微生物資源量的近40-45%。平台制定了微生物菌種資源的共性描述規範,制定了60個菌種資源描述規範和38套操作技術規程,在全國範圍內統一描述微生物資源,糾正了過去描述混亂的局面;將共享資源標註安全等級,規範了相關人員在製備操作和運輸菌種過程中的行為,以達到促進我國獸醫事業發展的社會效益、經濟效益的目的。